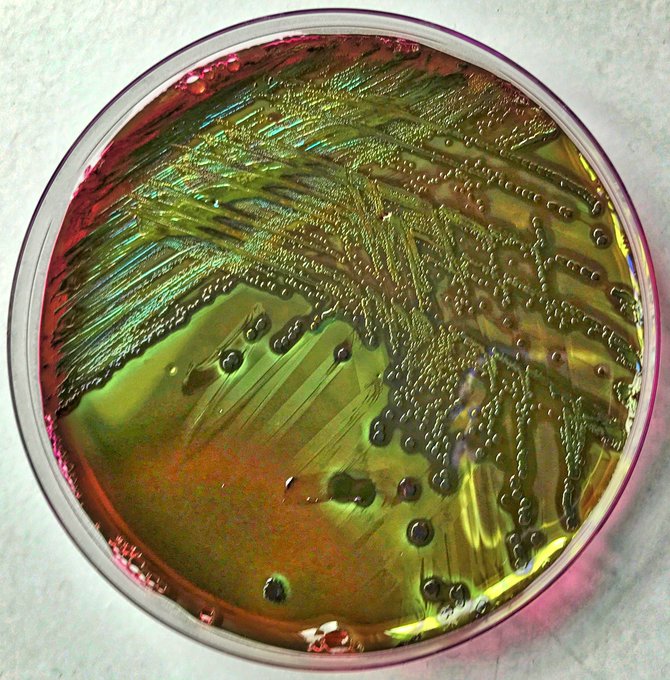

[m] Self Portrait: this self portrait has not been painted by my visible self but by the bacteria of my gut microbiome. Mixed with watercolours on growth agar & incubated overnight, my bacteria swarm over the media to move the paints, painting, illustrating their power & impact.
A bacterial tweet ! Multi-species bacterial messages and texts. All you see is bacterial. Lots of bacteria-bacteria interactions happening. #Bioart, #Bacterial tweets, #Bacterial Art
The Bacterial Manifesto! Made entirely from bacteria on their behalf. Letters and all.
Small Things Considered. These works explore the recent and much reported decline in insect numbers. Tracks made by flying insects at Buckland Abbey, Devon. An island of biological diversity. @BucklandAbbeyNT
BioAugmented Lace. Lace stained by the activity of an E. coli from my own gut microbiome.
Unique self-portraits made by my gut microbiome. Mixed with watercolours, the bacteria grow, travel and move the watercolours around the medium, similar to the way that an artist might paint, and revealing the usually unseen activity of my bacterial self https://t.co/RJUyUUSXJU
On bacteria that can "paint" using watercolours. I've tested many many bacterial strains for their ability to "paint" with watercolours, but of these so far, only Serratia marcescens (the red pigment) and Proteus mirabilis have shown this aptitude.
https://t.co/ZV1TD7mbEU
Bacterial Agency In Art. Sarah Roberts & I mixed her watercolours with a red pigmented bacterium. It moves the water colours and "paints"
On election day here's a bacterial manifesto! (made entirely from bacteria)